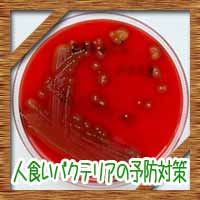

「全身にわたる不調」の記事一覧
- コタローの日常喫茶 TOP
- 健康・医療
- 病気・症状
- 全身にわたる不調
サブコンテンツ
サイドバー
当喫茶店のマスター

どうもこんにちは
サイト管理人のコタローと申します。
日常的に気になった情報
何かしらお得な情報
毎日の節約術、レシピ情報などなど
当サイトの管理人が気になった事
他の皆さんの気になっていそうなことを
お届けしていきます。
最近の投稿
カテゴリー
- パソコン・ソフトウェア
- ビジネス・経済
- マネー
- メンタル
- 不動産・住宅
- 健康・医療
- 出産
- 各季節のイベント
- 恋愛
- 料理
- 旅行・お出かけなど
- 生活・ライフスタイル
- 美容・ビューティ
- 育児・教育
- 語学・学習
- 趣味・娯楽